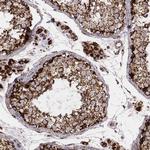
TUFM Antibody in Immunohistochemistry (Paraffin) (IHC (P))

Search
Invitrogen
TUFM Monoclonal Antibody (CL2243)
{{$productOrderCtrl.translations['antibody.pdp.commerceCard.promotion.promotions']}}
{{$productOrderCtrl.translations['antibody.pdp.commerceCard.promotion.viewpromo']}}
{{$productOrderCtrl.translations['antibody.pdp.commerceCard.promotion.promocode']}}: {{promo.promoCode}} {{promo.promoTitle}} {{promo.promoDescription}}. {{$productOrderCtrl.translations['antibody.pdp.commerceCard.promotion.learnmore']}}
图: 1 / 10
TUFM Antibody (MA5-31364) in ICC/IF

产品信息
MA5-31364
种属反应
宿主/亚型
分类
类型
克隆号
偶联物
形式
浓度
规格
纯化类型
保存液
内含物
保存条件
运输条件
RRID
产品详细信息
Immunogen sequence: AVDTYIPVPA RDLEKPFLLP VEAVYSVPGR GTVVTGTLER GILKKGDECE LLGHSKNIRT VVTGIEMFHK SLERAEAGDN LGALVRGLKR EDLRRGLVMV KPGSI
Highest antigen sequence indentity to the following orthologs: Mouse - 95%, Rat - 96%.
靶标信息
This gene encodes a protein which participates in protein translation in mitochondria. Mutations in this gene have been associated with combined oxidative phosphorylation deficiency resulting in lactic acidosis and fatal encephalopathy. A pseudogene has been identified on chromosome 17.
仅用于科研。不用于诊断过程。未经明确授权不得转售。
篇参考文献 (0)
生物信息学
蛋白别名: EF-Tu; Elongation factor Tu, mitochondrial; epididymis secretory sperm binding protein; mitochondrial elongation factor homolog; P43
基因别名: COXPD4; EF-TuMT; EFTU; P43; TUFM
UniProt ID: (Human) P49411
Entrez Gene ID: (Human) 7284




